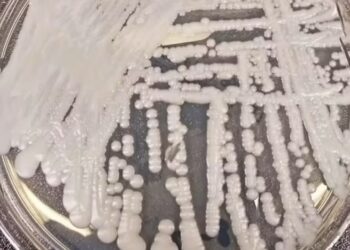

Destaque Principal
Band Verão destaca as belezas, cultura e sabores de Grossos/RN neste sábado (31)
O Band Verão 2026 chega a Grossos, no litoral potiguar, marcando o último programa da temporada com uma edição especial...
Leia MaisDetailsAlerta de saúde: Sesap confirma caso do superfungo Candida auris em paciente internado em Natal
Entenda o que é o fungo e os riscos para o sistema de saúde potiguar A Secretaria de Estado da...
Band Verão destaca as belezas, cultura e sabores de Grossos/RN neste sábado (31)
O Band Verão 2026 chega a Grossos, no litoral potiguar, marcando o último programa da temporada com uma edição especial...
Band Alagoas transmite ao vivo o Pinto da Madrugada e celebra 10 anos no Estado
A Band Alagoas realiza, no próximo dia 07 de fevereiro, a cobertura ao vivo da festa do Pinto da Madrugada,...
Natal Experience 2026 amplia line-up com mais quatro DJs e reforça proposta do evento
O verão potiguar ganha ainda mais força com a ampliação do line-up do Natal Experience 2026, que passa a contar...
PF e CGU cumprem 35 mandados no RN contra desvio de recursos públicos
Operação Mederi investiga esquema criminoso envolvendo contratos públicos para fornecimento de insumos à área da saúde
Beatriz Oliveira celebra aprovação em Medicina da UFRN em Pirangi
A aprovação de Beatriz Oliveira no curso de Medicina da UFRN foi comemorada com uma recepção no Porto Brasil, em...
Oncology Group inaugura mais uma unidade em Natal
Na noite de terça-feira, Petrópolis ganhou novos ares. O motivo foi a chegada da quarta unidade do Oncology Group em...
Redinha recebe ação inclusiva com apoio da Prefeitura do Natal
A Prefeitura do Natal apoia, pela primeira vez na Zona Norte, uma ação com estrutura inclusiva e acessível voltada à...
Vítima de capotamento em duna é resgatada por helicóptero em operação de risco no litoral sul do RN
Uma operação de resgate de alta complexidade foi realizada na noite deste domingo 25 no litoral sul potiguar, após o...
CARBONE EDUCAÇÃO REALIZA ACADEMY & CLUB CLASS COM FERNANDO MIRANDA NO DIA 5 DE FEVEREIRO
A Carbone Educação promove, no próximo dia 5 de fevereiro, mais uma edição do Academy & Club Class, um encontro...
Natal passa a contar com novo bairro após mudança nos limites de Candelária
A Zona Sul de Natal passa a contar oficialmente com um novo bairro. O prefeito Paulinho Freire sancionou a Lei...
Violência contra a mulher cresce 6,1% no RN; feminicídios e tentativas também aumentam em 2025
A Polícia Civil do Rio Grande do Norte PCRN divulgou dados alarmantes que apontam um aumento significativo nos crimes de...